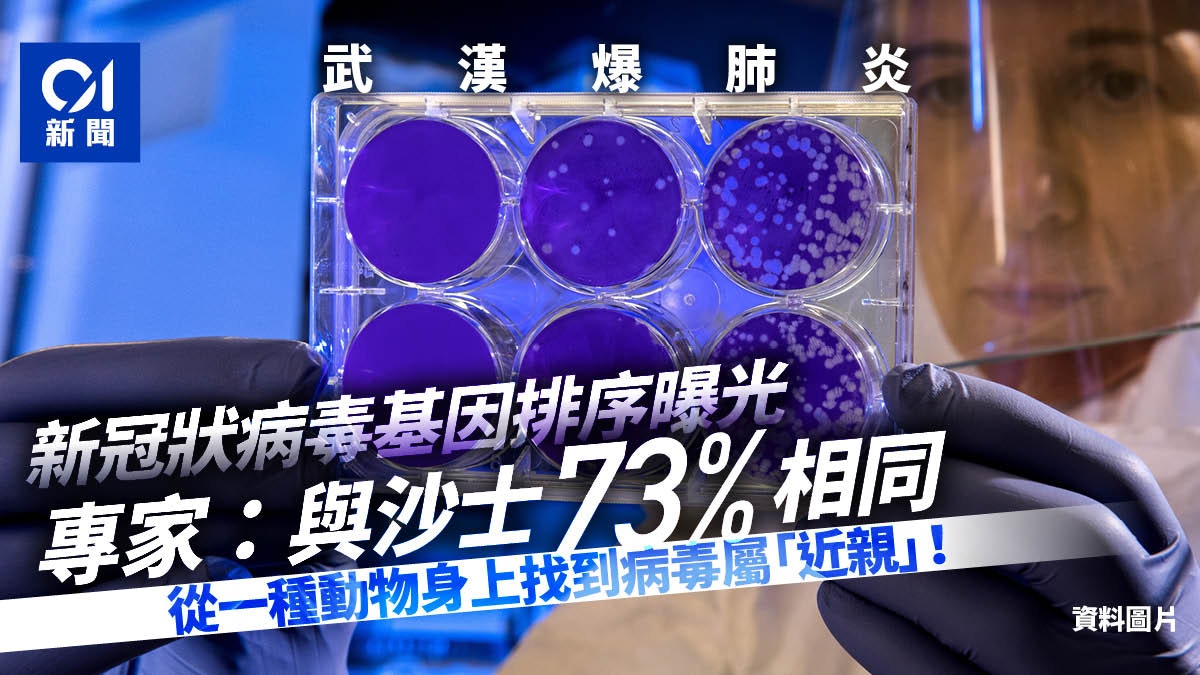
【武漢肺炎】冠狀病毒基因排序首曝光　專家：與沙士基因73%相同

中國當局早前公布,武漢不明肺炎初步判定由新型冠狀病毒引起。武漢市衛健委今早(11日)表示,初步診斷新型冠狀病毒感染的肺炎病例有41宗,其中2宗已出院、7宗重症、1宗死亡。醫務人員沒有發現相關病例,未發現明確的人傳人證據。
中文大學呼吸系統科講座教授許樹昌說,涉及武漢肺炎的新病毒屬於冠狀病毒2B分型,其基因排序與沙士病毒的基因有73%相同,而且與兩種從蝙蝠身上找到的病毒屬「近親」。
衞生署衞生防護中心總監黃加慶醫生今日(11日)下午2時會見傳媒,匯報武漢肺炎病例群組個案的最新進展。香港大學李嘉誠醫學院微生物學系傳染病學講座教授袁國勇教授亦會出席。







上海公共衛生臨床中心聯同武漢中心醫院、華中科技大學、武漢市疾病預防控制中心、中國疾病預防控制中心、悉尼大學等,公布其中一個武漢不明肺炎感染個案的基因排序。該基因排序已經儲存至基因庫。有關基因排序由上海復旦大學公共衛生臨床中心教授張永振委託悉尼大學的學者上載至醫學網站。
許樹昌稱,涉及武漢肺炎的新病毒屬於冠狀病毒2B分型,其基因排序與沙士病毒的基因有73%相同,而且與兩種從蝙蝠身上找到的病毒屬「近親」,包括一種是由香港大學過去發現的新型病毒。

許樹昌稱,涉及武漢肺炎的新病毒屬於冠狀病毒2B分型,其基因排序與沙士病毒的基因有73%相同。(資料圖片/盧翊銘攝)